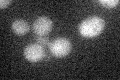
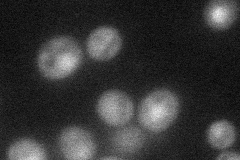
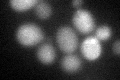

View description
Cell-cycle regulated activator of anaphase-promoting complex/cyclosome (APC/C), which is required for metaphase/anaphase transition; directs ubiquitination of mitotic cyclins, Pds1p, and other anaphase inhibitors; potential Cdc28p substrate
Localization:
Intensity:
Fold change:
Significance:
-
C’ GFP library in SD
nucleus:cytosol18.66 -
N' NOP1pr-GFP in SD
cytosol,nucleus36.8641 -
N' TEF2pr-mCherry in SD

missing0 -
N' NATIVEpr-GFP in SD

missing0 -
N' TEF2pr-VC and Cyto-VN in SD

#N/A0 -
C’ GFP library in SD+DTT
nucleus.cytosol21.161.13No -
C’ GFP library in SD+H2O2

nucleus.cytosol19.341.03No -
C’ GFP library in Starvation Media

nucleus,cytosol14.560.78No -
C’ GFP library on the background of Pup2-DaMP

nucleus:cytosol -
C’ GFP library on the background of CCT mutant

nucleus:cytosol21.25491.13861No
